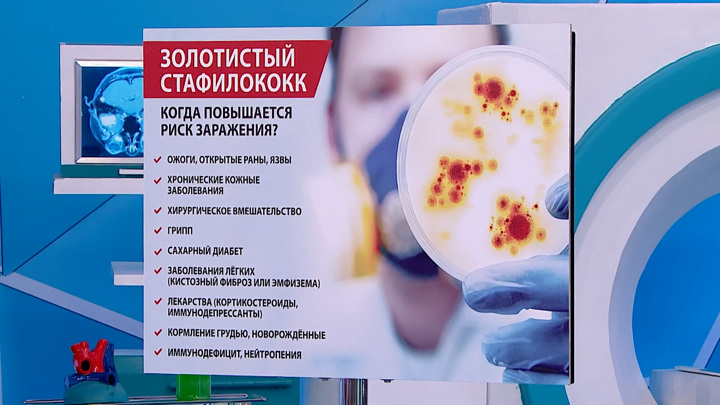

Около 40% людей сегодня являются носителями золотистого стафилококка. Как понять, что вы им заражены и почему против этой бактерии стали бессильны многие антибиотики – рассказал Александр Мясников в программе "О самом главном" на канале "Россия 1".
Угроза сегодняшнего дня, по словам теледоктора, это не ковид, как думают многие. Настоящим убийцей миллионов людей был и остается золотистый стафилококк.
Прежде всего, потому что стафилококковая инфекция является источником многих смертельных болезней. В частности, такого осложнения, как синдром токсического шока. Заражение золотистым стафилококком может привести заболеванию сердца – инфекционного эндокардита, а также остеомиелиту – воспалению костной ткани.
И вообще, причиной многих воспалительных заболеваний кожи, как правило, становится золотистый стафилококк. При том, что бактерия опасна сама по себе, она еще и постоянно мутирует. Из-за бесконтрольного приема антибиотиков золотистый стафилококк стал устойчив почти ко всем из них. И лечить вызванные им заболевания для медиков сегодня – большая проблема.
Чтобы не подвергать себя риску подхватить золотистый стафилококк, Мясников посоветовал не посещать поликлиники и больницы без крайне необходимости.
"Больница – место повышенной инфекционной опасности. Почему пневмонии делятся на внебольничную и внутрибольничную? Последняя может убить. Так и стафилококковая инфекция. Внутри больницы она очень опасна, потому что проникает в организм самыми разными способами. И ее мало, что может остановить, – предупредил доктор.
Бактерия не только устойчива к антибиотикам, от нее не спасает ни этиловый спирт, ни перекись водорода, ни санитайзеры. Наоборот, если пользоваться ими слишком часто можно уничтожить собственный микробиом, который как раз и способен защитить человека от золотистого стафилококка.
По каким внешним признакам можно определить, что у человека есть заболевания, вызванные золотистым стафилококком, смотрите в полном выпуске программы "О самом главном" на канале "Россия 1".
